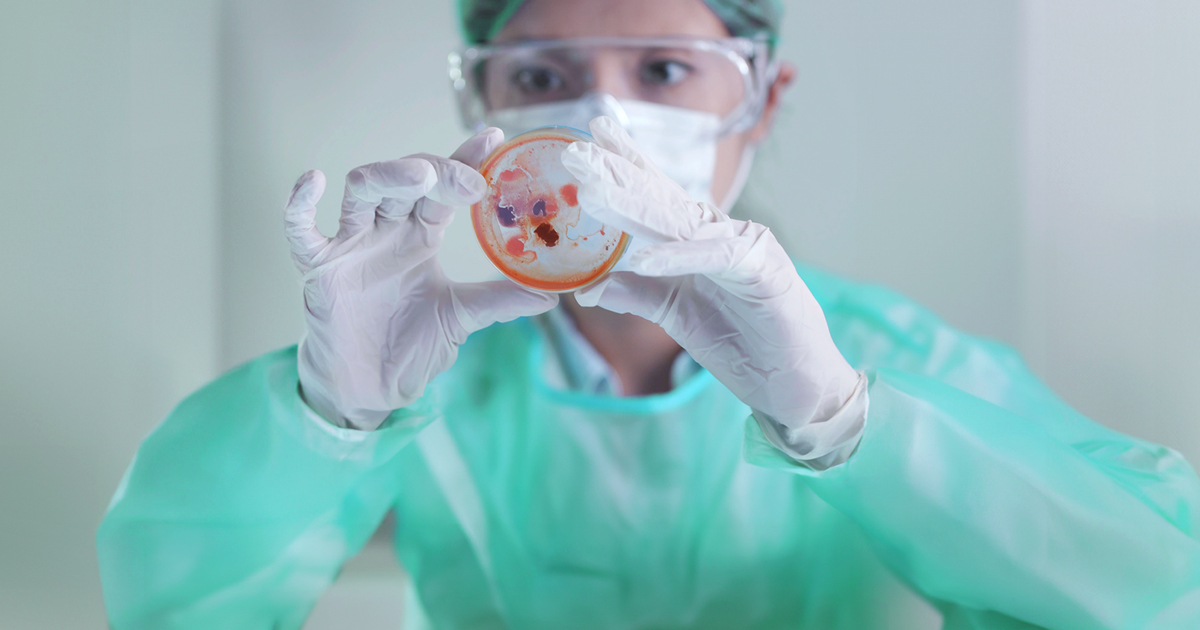

Second Antimicrobial Resistance (AMR) Symposium AMR Unmasked: Leveraging Diagnostics, AMS, and IC for a Safer Tomorrow
LAU Medical Center–Rizk Hospital, Dr. Michel E. Mawad Block D, auditorium, 5th floor
This symposium aims to address the growing global threat of antimicrobial resistance by exploring its clinical, pharmacologic, and systems-level drivers across diverse healthcare settings. The objectives are:
- Analyze the multifaceted determinants of antimicrobial resistance in clinical practice and healthcare systems
- Evaluate evidence-based strategies for appropriate antibiotic use, diagnostics, and management of drug-resistant infections
- Integrate interdisciplinary perspectives from medicine, pharmacy, public health, and policy to strengthen antimicrobial stewardship and improve patient outcomes
Join renowned experts from Lebanon and the United States as they examine antimicrobial resistance through clinical, regulatory, and One Health lenses.
This activity is designed for physicians, pharmacists, infectious disease specialists, internal and family medicine physicians, trainees, and allied healthcare professionals.
Certificates of attendance will be issued by the LAU CME Office. Participants are also eligible to receive CME credits, pending approval by the Lebanese Order of Physicians.
PROGRAM
| 16:00 - 16:05 | Symposium Opening and Welcome |
Roula Husni Samaha, MD Chair of the Internal Medicine Department LAU Gilbert and Rose-Marie Chagoury School of Medicine |
| 16:09 - 16:14 | Melhem Scientific Vision: Building a Global AMR Innovation Ecosystem |
Mr. Nehme Melhem CEO, Entrepreneur Melhem Holdings |
| 16:15 - 16:35 | The Regional Burden of AMR | Kabas Abou Jahjah, PharmD |
| 16:40 - 17:00 | Rapid Diagnostics and Their Role in Mitigating AMR | Ziad Daoud, PhD |
| 17: 05 - 17:25 | National Action Plans on Antimicrobial Resistance in LMICs: Progress, Barriers, and the Way Forward |
Rima Moghnieh, MD Head, Division of Infectious Diseases LAU Gilbert and Rose-Marie Chagoury School of Medicine |
| 17:25 - 17:40 | Break | Break |
| 17:45 - 18:10 | The Role of Pharmacists in Antimicrobial Stewardship |
Hanine Mansour, BS Pharm, PharmD, BCPS, BCIDP Wissam Kabbara, BS Pharm, PharmD, BCPS Roula Husni Samaha, MD |
| 18:16 - 18:35 | The Global Burden of AMR and the Role of Advanced AI in Surveillance | Robert A. Bonomo, MD |
| 18:40 - 19:00 | The One Health Approach: AMR in Animals and the Environment | Lydia Aoun-Barakat, MD |
| 19:00 - 19:10 | Closing remarks | Mr. Nehme Melhem |